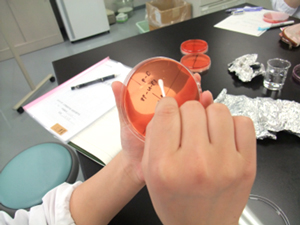

新着ニュース
2014/06/05
- 教育研究情報
「食品衛生学実験」 vol.11 ~黄色ブドウ球菌の定性試験~

人間健康学部 健康栄養学科 教授 髙木 勝広
今回は、黄色ブドウ球菌の定性試験です。
黄色ブドウ球菌は直径1μmの球菌で、ブドウの房状に細胞が配列しているのが特徴です。
ヒトや動物の鼻、皮膚などにしばしばみられ、化膿を起こす代表的な細菌です。
手指に化膿がある人が調理したところ、黄色ブドウ球菌が食品中で増殖し、毒素を作り、食中毒を起こすことが今までありました。
したがって予防には、調理環境(調理関係者の手指、調理器具など)の日常的な細菌検査を行い、衛生意識の向上、食品への汚染を防止が重要といえます。
ということで今回の実験は、学生自身を試料とし、黄色ブドウ球菌の検査を行いました。
検査用培地はマンニット食塩寒天培地で、卵黄を入れて調製します。
培地に卵黄を加えると、黄色ブドウ球菌が増殖した際、卵黄と反応するので、コロニーの周りに特殊な反応物(白濁環)が出てきて、判定しやすくなるという仕組みになっています。
培地が完成したら、写真のようにマジックで培地を4つに分け、そして自身のどの場所を調べるのかを決めます。
準備が整ったら実験開始です。綿棒でしっかり拭き取り、培地に塗りつけます。
今回の実験は、個人が実験台になるので、いつもと違って、どきどきかなと思いましたが、しっかり鼻に綿棒を入れて実験していました(笑)。
関連する教員



